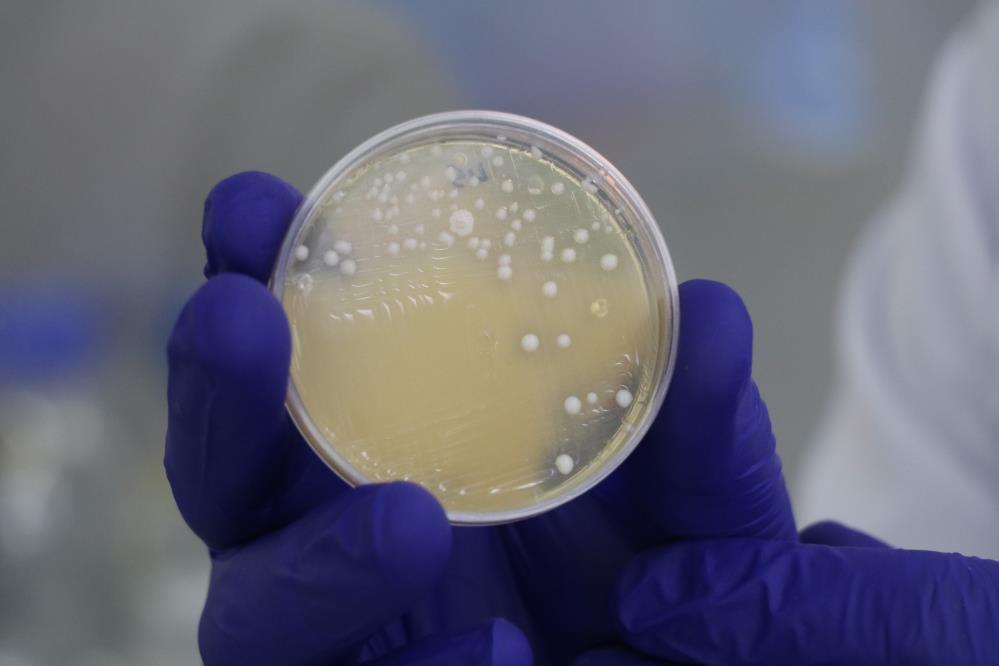

Sivas Bilim ve Teknoloji Üniversitesi (SBTÜ), yürüttüğü dikkat çekici çalışmayla turşularda doğal olarak oluşan laktik asit bakterilerinin, bitki hastalıklarına karşı biyolojik bir mücadele aracı olabileceğini ortaya koydu. Bu buluş, geleneksel yöntemlerle yapılan turşuların tarımda kimyasal ilaçlara alternatif bir çözüm olabileceğini gündeme taşıdı.

Türk mutfağının yüzyıllardır vazgeçilmezi olan turşular, sadece lezzetleriyle değil, içerdiği yararlı bakterilerle de artık tarımsal biyoteknolojide yerini alıyor. SBTÜ Tarım Bilimleri ve Teknoloji Fakültesi Bitki Koruma Bölümü’nden Dr. Öğr. Üyesi Mustafa Akbaba’nın yürüttüğü çalışmada, farklı illerden temin edilen 50’ye yakın ev yapımı turşu örneği detaylı olarak incelendi.
Laktik asit bakterileri pestisite alternatif olabilir
Turşuların 3 ila 6 ay boyunca açılmadan doğal fermantasyona bırakıldığı örneklerde, sadece uygun şartlarda üretilenlerde laktik asit bakterisine rastlandı. Akbaba, bu bakterilerin özellikle mantar ve bakteri kaynaklı bitki hastalıklarıyla mücadelede ciddi potansiyele sahip olduğunu vurguladı. Geleneksel yöntemlerle hazırlanan biber, salatalık, lahana, şeker pancarı ve hatta kavun-karpuz turşularından elde edilen bakteriler laboratuvar ortamında izole edilerek test edildi.
Domateste patojenlere karşı denenecek
Yoğun pestisit kullanımının görüldüğü domates üretiminde, bu bakterilerin hastalık yapıcı mikroorganizmalara karşı etkili olup olmayacağı araştırılacak. Laboratuvar testlerinin ardından başarılı bulunan izolatlar, saha koşullarında da denenecek. Hedef, hem ürün kalitesini artırmak hem de çevre ve insan sağlığına zarar vermeyen doğal çözümler geliştirmek.
Ev yapımı turşuların gücü tarımı değiştirebilir
Akbaba, yürüttükleri çalışmada Kahramanmaraş, Malatya, Ordu, Kayseri, Yozgat ve Tokat gibi illerde vatandaşların kendi evlerinde katkısız şekilde kurduğu geleneksel turşulardan faydalandıklarını belirtti. Uygun şekilde fermente edilen bu turşular, içerdikleri yararlı mikroorganizmalar sayesinde sadece sofralarımızı değil, tarlalarımızı da koruyabilir hale geliyor.
SBTÜ’den tarım için yeni projeler yolda
Elde edilen veriler doğrultusunda SBTÜ bünyesinde yeni projeler geliştirilmesi hedefleniyor. Başarılı sonuç veren bakterilerle, pestisit kullanımını azaltacak biyolojik çözümler oluşturulması planlanıyor. Bu yaklaşım hem sürdürülebilir tarım politikalarına katkı sağlayacak hem de doğal ürün üretimini destekleyecek.